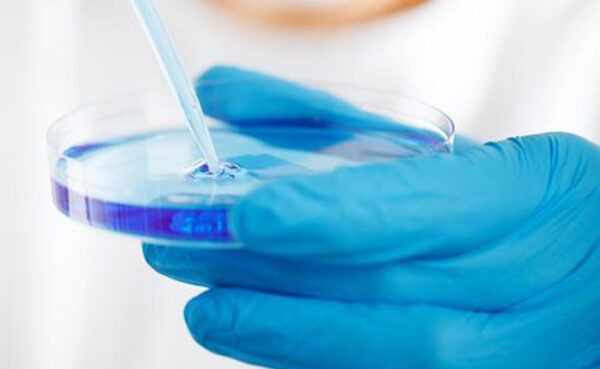

KI en stamselle of Karoo-skaaptjoppies? Enkele opmerkings oor kunsmatige vleisproduksie
“Die voorstanders van kunsmatige vleisproduksie (KVP) argumenteer dat hierdie vernuwende tegnologie ʼn kritieke bydrae behoort te lewer ten opsigte van dierewelsyn en terselfdertyd ʼn positiewe impak op omgewingsbewaring en menslike gesondheid sal uitoefen.”
1 Comment